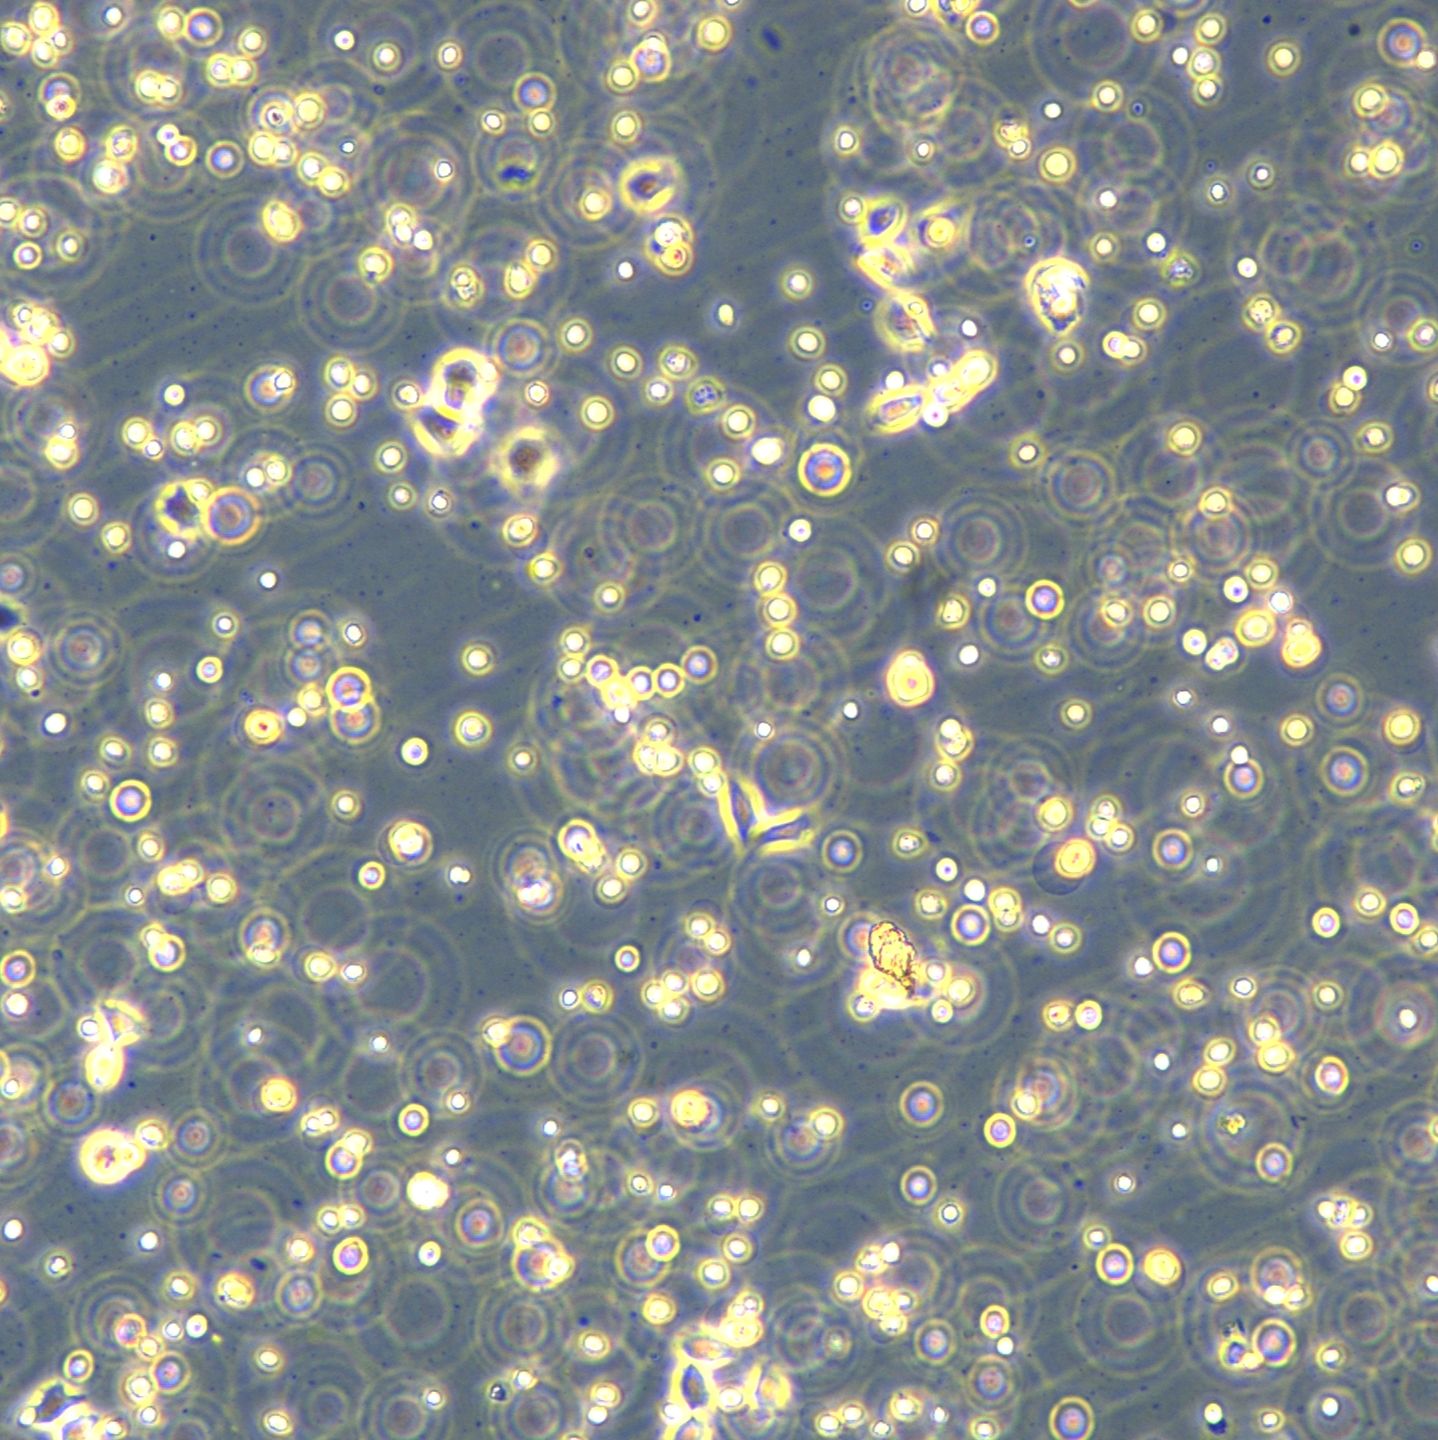
产品封面图

相关产品推荐更多 >
万千商家帮你免费找货
0 人在求购买到急需产品
- 详细信息
- 文献和实验
- 技术资料
- 英文名:
SK-LU-1
- 库存:
99
- 组织来源:
肺(Lung)
- 相关疾病:
肺腺癌(Lung adenocarcinoma)
- 物种来源:
人源(Homo sapiens)
- 细胞形态:
表皮细胞(Epithelial)
- 年限:
60岁(60 Years)
- 生长状态:
贴壁生长(Adherent)
- 规格:
T25/冻存管


| 规格 | T25 |
| 货号 | CTCC-400-0036 |
| 种属 | 人源(Homo sapiens) |
| 组织来源 | 肺(Lung) |
| 疾病 | 肺腺癌(Lung adenocarcinoma) |
| 年龄 | 60岁(60 Years) |
| 培养体系 | 该细胞系培养所用基本培养基为 Dulbecco’s Modified Eagle’s Medium (DMEM), 配置完全培养基时需加入 10%FBS,1% Anti-Anti。 |
| 细胞形态 | 表皮细胞(Epithelial) |
| 生长特性 | 贴壁生长(Adherent) |
风险提示:丁香通仅作为第三方平台,为商家信息发布提供平台空间。用户咨询产品时请注意保护个人信息及财产安全,合理判断,谨慎选购商品,商家和用户对交易行为负责。对于医疗器械类产品,请先查证核实企业经营资质和医疗器械产品注册证情况。
文献和实验刚开始养SK-BR-3时,细胞状态不是很好,贴壁也不均匀,于是开始想办法,考虑是不是吹打的不够,或是传得过多,或是其它的什么,后来发现的确如此,细胞的生长状态与传代的方法有很密切的联系。我的传代方法是:以50平方厘米培养瓶为例,待细胞长满瓶底70%-80%1 、吸除或倒掉瓶内旧培养基。2 、PBS 5ml加入培养瓶,轻轻晃动培养瓶,让PBS流遍细胞表面,倒掉。3 、PBS 5ml加入培养瓶重复洗一次,倒掉。4 、加入1ml胰蛋白酶消化液,轻轻摇动培养瓶,使消化液流遍所有细胞表面,然后置37度
1. Inoculate the entire colony in 5 ml YPD culture O.N. or 12 hours 2. Dilute into YPA medium (1% yeast extract, 2% Bacto-peptone, 2%KOAC) to OD600~ 0.2, Vigorous shaking. 3. For ts mutants, ~15hours at 23C, others ~10 hours at 30C
适用标准:GB/T3536-91(克力夫兰开口杯法)GB/T267-88 产品说明: 本仪器采用当代先进技术,集机械、光学,电子及计算机技术于一体,结构紧凑。可自动完成石油产品开口闪点的测试,实验过程中的升温速率及扫描点火动作由微机控制自动进行,油气闪火时,检测系统自动捕捉并记录闪点温度。对闪点数据进行自动气压修正,并以规范的格式打印输出,还可根据需要重复打印数据。 本仪器可由计算机监控(无线/有线通讯方式,由用户选配)。 本仪器结构合理,性能稳定,操作简单,是理想的分析